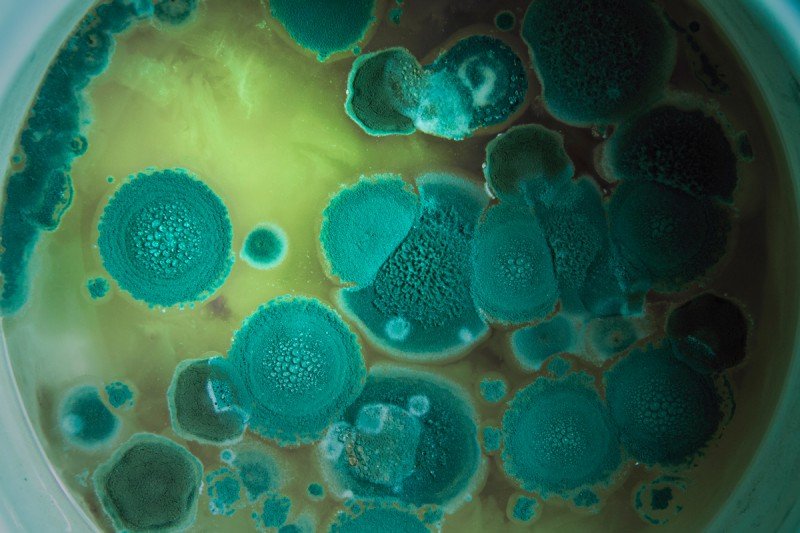

Грибы рода аспергиллус: фотогалерея и описание





































-testleri.jpg)

Раздел: Природная галерея